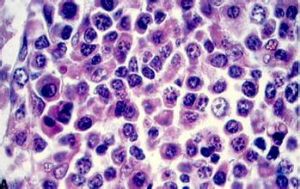
漿細胞
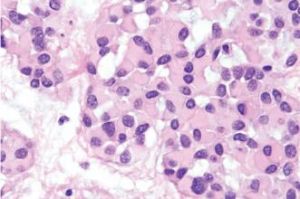
漿細胞

基本介紹
 漿細胞
漿細胞此酶分解了抗原後,抗原的碎片就付著在MHC II(主要組織相容性複合體 II)分子上,並出現在其外表面。一旦出現在MHC II分子外表面,CD4+輔助型T細胞就和MHC II/抗原分子結合,並激活B細胞。該激活過程包括B細胞異化為漿細胞以及緊接下來的抗體生成過程以消滅抗原。
漿細胞具有合成、貯存抗體即免疫球蛋白(immunoglobulin)的功能,參與體液免疫反應。免疫球蛋白主要在粗面內質網池內形成,用免疫螢光技術已證實注射一種抗原到機體後,相應的抗體首先在漿細胞的細胞質中出現。
存在位置
 漿細胞
漿細胞正常機體漿細胞存在在脾、淋巴結的相應組織結構處,漿細胞生成抗體並將它們釋放到周圍的組織液中,通過淋巴結血液通路開放的循環匯集成髓靜脈,髓靜脈進入小梁靜脈,最後匯集成靜脈出淋巴結;輸入淋巴管經淋巴結後以輸出淋巴管出淋巴結,故少部分抗體可直接進入淋巴。所以抗體先進入組織液,而不是直接分布在血漿中。抗體以開放於髓竇血液通路直接匯入靜脈而進入血漿的。抗體可以分布在淋巴內。
形態
漿細胞直徑10-20μ;核較小,占細胞的1/2以下,多偏於一側,偶可見雙核;染色質粗密、聚集成堆、常染成紫丁香色、不均勻,在近核處一邊常伸出半月狀淡染區;漿中偶見有空泡或有泡沫感。
原始漿細胞直徑14-20μ;核較大,約占細胞2/3,圓或橢圓形,常偏於一側;染色質細緻、呈顆粒狀,均勻分散或呈細網狀。核仁2-5個,淡藍色,不顯著。胞漿較其它原始細胞為多,深藍而不透明,近核處著色較淺,無顆粒,偶可見到空泡。原始漿細胞在正常骨髓中極少見到,只有在多發性骨髓瘤和漿細胞白血病時才可大量存在,並有形態變異。
增殖方式
漿細胞
漿細胞(漿細胞系統包括原始漿細胞、幼漿細胞、Russell小體、Dutcher小體和火焰狀細胞等部分。)
症狀
診斷要點
1.病因存在
2.病變為l一3mm直徑大小、淡紅色或略帶黃色的小結節,可互相融合或重疊成臘腸狀。隆起而境界不清,不引起潰瘍。
3.多見於上險結膜及穹宮窿部結膜,使上險肥厚而下垂。也可發生在下險、球結膜、角膜。
4.組織學檢查:由聚集成堆的漿細胞組成,其中常有玻璃樣或澱粉樣變性,並非真正腫瘤。
治療
手術切除,但易復發。
起源於B細胞,而從功能上來看應是一些效應B細胞。
分泌方式
漿細胞
漿細胞(1)局部分泌:這是所有分泌性細胞的共有分泌方式。在漿細胞內質網囊腔中合成的免疫球蛋白分子,先以芽生的方式形成許多小囊泡,然後輸送到高爾基複合體進行加工、濃縮和貯存,最後,充滿免疫球蛋白分子的小囊泡游離到細胞質膜的內表面,與細胞質膜相溶合併通過反向吞噬,將內含物分泌到細胞外。
(2)頂質分泌:一部分細胞質向外突出,形成小囊狀物,繼而小囊狀物脫落並將其中的免疫球蛋白分子釋放出來。
(3)全質分泌:漿細胞溶解,其中所含免疫球蛋白分子被全部釋放出來。此方式不是主要的分泌方式。

